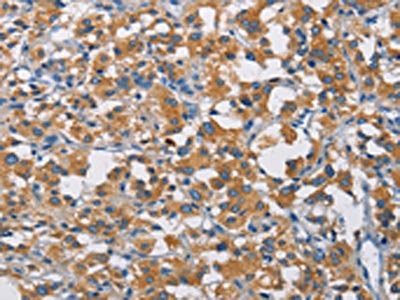

CRTAM Antibody
-
中文名稱:CRTAM兔多克隆抗體
-
貨號:CSB-PA725805
-
規格:¥1100
-
圖片:
-
其他:
產品詳情
-
Uniprot No.:
-
基因名:
-
別名:CRTAM; Cytotoxic and regulatory T-cell molecule; Class-I MHC-restricted T-cell-associated molecule; CD antigen CD355
-
宿主:Rabbit
-
反應種屬:Human
-
免疫原:Fusion protein of Human CRTAM
-
免疫原種屬:Homo sapiens (Human)
-
標記方式:Non-conjugated
-
抗體亞型:IgG
-
純化方式:Antigen affinity purification
-
濃度:It differs from different batches. Please contact us to confirm it.
-
保存緩沖液:-20°C, pH7.4 PBS, 0.05% NaN3, 40% Glycerol
-
產品提供形式:Liquid
-
應用范圍:ELISA,IHC
-
推薦稀釋比:
Application Recommended Dilution ELISA 1:2000-1:5000 IHC 1:25-1:100 -
Protocols:
-
儲存條件:Upon receipt, store at -20°C or -80°C. Avoid repeated freeze.
-
貨期:Basically, we can dispatch the products out in 1-3 working days after receiving your orders. Delivery time maybe differs from different purchasing way or location, please kindly consult your local distributors for specific delivery time.
-
用途:For Research Use Only. Not for use in diagnostic or therapeutic procedures.
相關產品
靶點詳情
-
功能:Mediates heterophilic cell-cell adhesion which regulates the activation, differentiation and tissue retention of various T-cell subsets. Interaction with CADM1 promotes natural killer (NK) cell cytotoxicity and IFNG/interferon-gamma secretion by CD8+ T-cells in vitro as well as NK cell-mediated rejection of tumors expressing CADM1 in vivo. Regulates CD8+ T-cell proliferation in response to T-cell receptor (TCR) activation. Appears to be dispensable for CD8+ T-cell-mediated cytotoxicity. Interaction with SCRIB promotes the late phase of cellular polarization of a subset of CD4+ T-cells, which in turn regulates TCR-mediated proliferation and IFNG, IL17 and IL22 production. By interacting with CADM1 on CD8+ dendritic cells, regulates the retention of activated CD8+ T-cells within the draining lymph node. Required for the intestinal retention of intraepithelial CD4+ CD8+ T-cells and, to a lesser extent, intraepithelial and lamina propria CD8+ T-cells and CD4+ T-cells. Interaction with CADM1 promotes the adhesion to gut-associated CD103+ dendritic cells, which may facilitate the expression of gut-homing and adhesion molecules on T-cells and the conversion of CD4+ T-cells into CD4+ CD8+ T-cells.
-
基因功能參考文獻:
- These results reveal that CRTAM is critical to instruct the differentiation of CD4(+)CTL through the induction of Eomes and CTL-related gene. PMID: 26694968
- CRTAM is negatively regulated by ZEB1 in T cells. PMID: 25910959
- Case-control studies reveal malignant mesothelioma risk associated with variants in the SDK1, CRTAM and RASGRF2 genes. PMID: 23827383
- The cell adhesion molecule Necl-2 competitively binds the immune receptor CRTAM. PMID: 23871486
- The expression of CRTAM in activated Vgamma9Vdelta2 T cells is quickly downregulated following interaction with Necl-2 on tumor cells. PMID: 23530148
- Three common variants in the class I MHC-restricted T cell-associated molecule gene were identified that were associated with an increased rate of asthma exacerbations based on the presence of a low circulating vitamin D level. PMID: 22051697
- Results show that CRTAM is a molecule involved in epithelial cell adhesion. PMID: 20556794
- Necl2/CRTAM molecular pair could regulate a large panel of cell/cell interactions both within and outside of the immune system PMID: 15781451
- NK cells and T8 cells recognize Necl-2 through CRTAM, expressed only on activated cells. CRTAM-Necl-2 interactions promote cytotoxicity of NK cells and IFN-gamma secretion of T8 cells as well as NK cell-mediated rejection of tumors expressing Necl-2 PMID: 15811952
- CRTAM expression is driven by the JNK-AP-1 signaling pathway. PMID: 19695707
顯示更多
收起更多
-
亞細胞定位:Cell membrane; Single-pass type I membrane protein.
-
蛋白家族:Nectin family
-
組織特異性:In the immune system, expression is restricted to activated class-I MHC-restricted cells, including NKT and CD8 T-cells. Strongly expressed in spleen, thymus, small intestine, peripheral blood leukocyte, and in Purkinje neurons in cerebellum. Expressed at
-
數據庫鏈接:
Most popular with customers
-
-
YWHAB Recombinant Monoclonal Antibody
Applications: ELISA, WB, IHC, IF, FC
Species Reactivity: Human, Mouse, Rat
-
Phospho-YAP1 (S127) Recombinant Monoclonal Antibody
Applications: ELISA, WB, IHC
Species Reactivity: Human
-
-
-
-
-